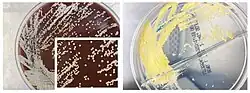

Nocardia brasiliensis
| Nocardia brasiliensis | |
|---|---|
| |
| Scientific classification | |
| Domain: | Bacteria |
| Kingdom: | Bacillati |
| Phylum: | Actinomycetota |
| Class: | Actinomycetes |
| Order: | Mycobacteriales |
| Family: | Nocardiaceae |
| Genus: | Nocardia |
| Species: | N. brasiliensis
|
| Binomial name | |
| Nocardia brasiliensis (Lindenberg 1909) Pinoy 1913 (Approved Lists 1980)
| |
Nocardia brasiliensis is a species of Nocardia. As with most members of Actinomycetota, they contain high guanine and cytosine content.[1] It can cause nocardiosis.[2]
References
- ^ "Nocardia pseudobrasiliensis". Archived from the original on 2013-06-07. Retrieved 2012-11-18.
- ^ Fukuda H, Saotome A, Usami N, Urushibata O, Mukai H (June 2008). "Lymphocutaneous type of nocardiosis caused by Nocardia brasiliensis: a case report and review of primary cutaneous nocardiosis caused by N. brasiliensis reported in Japan". J. Dermatol. 35 (6): 346–53. doi:10.1111/j.1346-8138.2008.00482.x. PMID 18578712. S2CID 588691.
Further reading
- Meester, Irene; Geovanni Rosas-Taraco, Adrian; Cesar Salinas-Carmona, Mario (June 17, 2014). "Nocardia brasiliensis Induces Formation of Foamy Macrophages and Dendritic Cells In Vitro and In Vivo". PLOS ONE. 9 (6): e100064. doi:10.1371/journal.pone.0100064. PMC 4061056. PMID 24936860.
External links